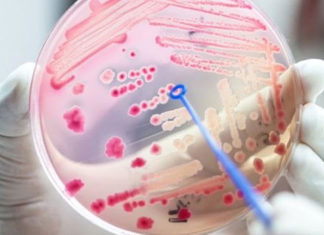
Sepse: importância do diagnóstico precoce e preocupação com a COVID-19 SEPSE

Missão do Sicredi no Haiti recebe reconhecimento internacional
Os integrantes da missão realizada pelo Sicredi no Haiti, em 2019, receberam, no último dia 22 de setembro, um reconhecimento do Conselho Mundial das Cooperativas de Crédito (WOCCU) pelo...
Metade das crianças de até 4 anos vive em insegurança alimentar
Metade das crianças menores de 5 anos do país viviam em domicílios com algum grau de insegurança alimentar em 2017-2018. Dados divulgados no último dia 17 pelo IBGE (Instituto...
Senai prevê 13 novas ocupações em alta no pós-pandemia
A pandemia de Covid-19 acelerou tendências e deve criar mais oportunidades de emprego para profissionais de tecnologia e logística, de acordo com estudo feito pelo Senai. Entre os novos...
Vacinação contra febre aftosa já imunizou 166 milhões de animais
Dados parciais da primeira etapa de vacinação contra a febre aftosa em 2020 mostraram cobertura vacinal de 97,81% do rebanho de bovinos e bubalinos de todas as idades. No total, segundo...
Prazo para registro de candidatura termina neste sábado, dia 26
Eleições 2020
O TSE (Tribunal Superior Eleitoral) alerta que este sábado, dia 26, é o último dia para os partidos políticos e as coligações apresentarem à Justiça Eleitoral, até as...
Sepse: importância do diagnóstico precoce e preocupação com a COVID-19
Dia 13 de setembro é o Dia Mundial da Sepse, data que lembra a importância da atenção, precaução e cuidado para evitar a Sepse. A doença é caracterizada, inicialmente,...
Sicredi inicia pré-cadastro dos associados para adesão ao Pix
O Sicredi iniciou pré-cadastramento dos associados interessados em vincular sua conta na instituição financeira cooperativa ao Pix, sistema de pagamentos instantâneos do Banco Central do Brasil, que começa a...
Campanha alerta para problemas de saúde mental na pandemia
A campanha Setembro Amarelo, que debate mundialmente a prevenção ao suicídio, traz este ano um componente a mais como fator de risco para as questões ligadas à saúde mental,...
Venda de subsidiárias da Petrobrás podem ter impactos profundos no Paraná
A privatização das subsidiárias da Petrobrás no Paraná pode resultar em impactos sociais e econômicos profundo no estado, afirmaram especialistas que participaram de uma audiência pública remota organizada pela...
Partidos políticos definem em convenção candidatos até a próxima quarta-feira, dia 16
Os partidos políticos têm até a próxima quarta-feira, dia 16, para realizar as convenções para definir as coligações para oficializar a escolha dos candidatos às eleições 2020 aos cargos...